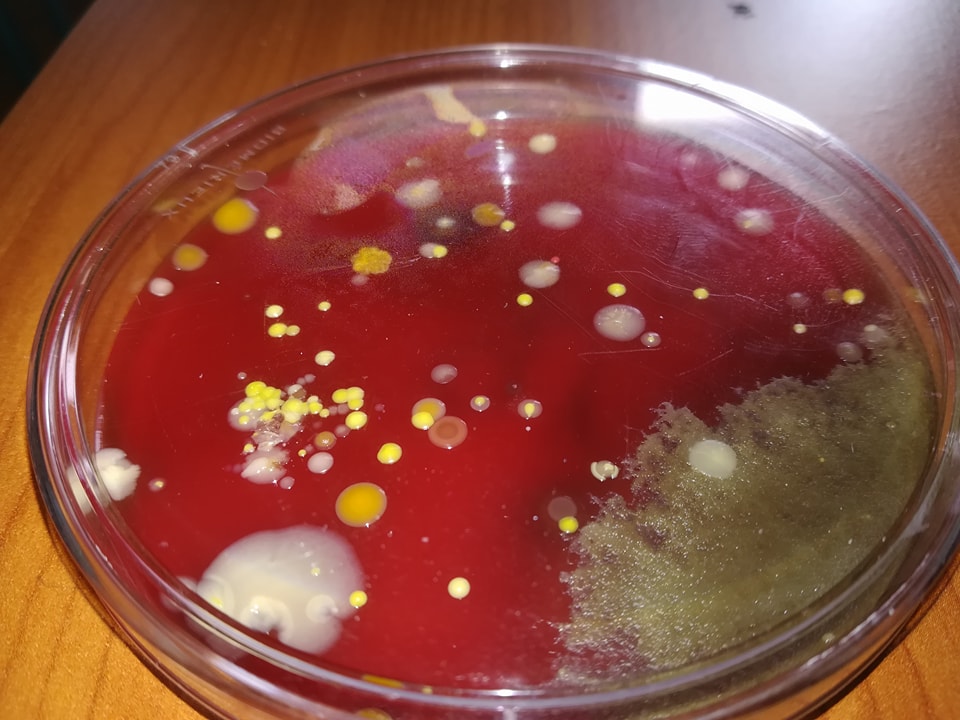
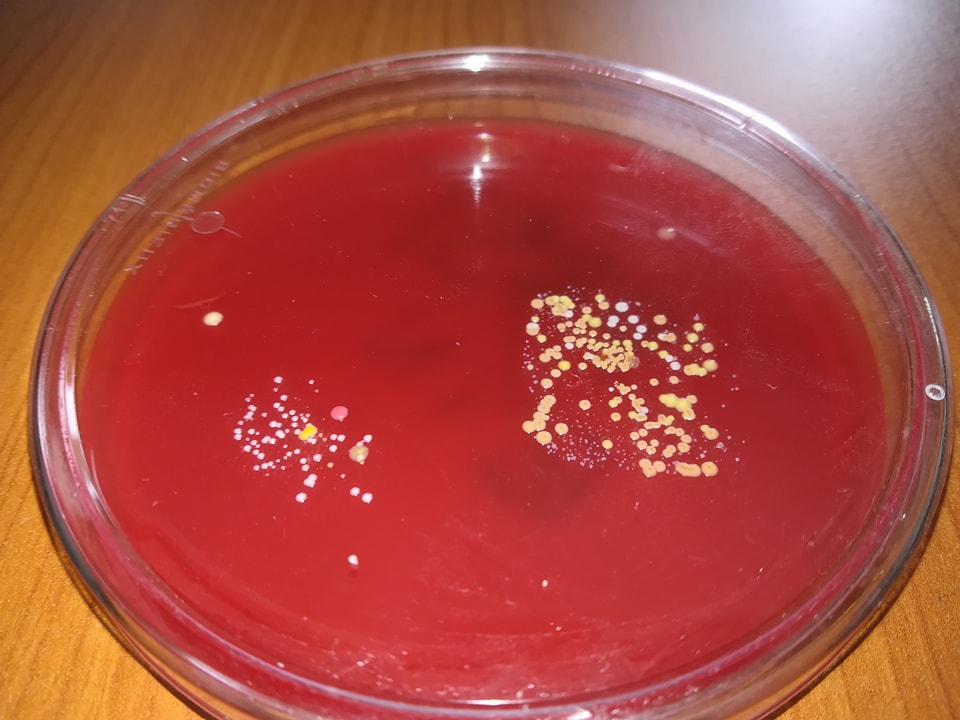

Vijesti
Bakterije će imati posljednju riječ
Autor: Đurđica Katanec, 25. 2. 2018.
U jeku zime, različitih oboljenja i zaraza, donosimo zanimljiv članak naših biologa.
"Bakterije su svugdje. Bakterije su svemoćne. Bakterije će imati posljednju riječ", izjavio je poznati mikrobiolog Louis Pasteur.

Bakterija (čista kultura) Bakterija - E. coli (čista kultura)
Uglavnom nismo svjesni da su bakterije prisutne svugdje oko nas, u nama te na nama. Malo istraživanje o prisutnosti bakterija gotovo svugdje proveli su učenici 1. G te učenici izborne nastave ekologije. Rezultati istraživanja su učenicima bili izuzetno interesantni pa su dio foto-dokumentacije odlučili podijeliti s javnošću. Možda će jedan dio čitateljstva određene fotografije o prisutnosti bakterija i zaprepastiti, ali važno je istaknuti da nema ničeg specijalno alarmantnog.
Možda nekoga ova foto-dokumentacija potakne na daljnja istraživanja prekrasnog svijeta mikroorganizama pojedinačno nevidljivih našem oku.
Evo fotografija do kojih su došli naši učenici prilikom istraživanja prisutnosti bakterija u njihovoj neposrednoj okolini.

Foto: Nika Hoblaj i Julija Zvonar
VIRTUALNA ŠETNJA
UPISI u 1. razred za 2025./2026. školsku godinu
UPISI FILM - (za osmaše)
UPUTE ZA ZAVRŠNI RAD
Kalendar
| « Studeni 2025 » | ||||||
| Po | Ut | Sr | Če | Pe | Su | Ne |
| 27 | 28 | 29 | 30 | 31 | 1 | 2 |
| 3 | 4 | 5 | 6 | 7 | 8 | 9 |
| 10 | 11 | 12 | 13 | 14 | 15 | 16 |
| 17 | 18 | 19 | 20 | 21 | 22 | 23 |
| 24 | 25 | 26 | 27 | 28 | 29 | 30 |
| 1 | 2 | 3 | 4 | 5 | 6 | 7 |
FILM
Korisni linkovi
Brojač posjeta
Ispis statistike od 25. 10. 2012.
Ukupno: 15507691
Ukupno: 15507691








.png)
.png)








